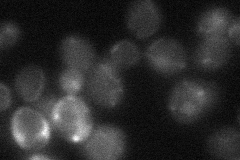
YKL192C

View description
Mitochondrial matrix acyl carrier protein, involved in biosynthesis of octanoate, which is a precursor to lipoic acid; activated by phosphopantetheinylation catalyzed by Ppt2p
Localization:
Intensity:
Fold change:
Significance:
-
C’ GFP library in SD

mitochondria222.89 -
N' NOP1pr-GFP in SD

mitochondria167.805 -
N' TEF2pr-mCherry in SD

mitochondria451.258 -
N' NATIVEpr-GFP in SD
mitochondria24.1103 -
N' TEF2pr-VC and Cyto-VN in SD

#N/A0 -
C’ GFP library in SD+DTT

mitochondria264.391.18No -
C’ GFP library in SD+H2O2

mitochondria121.830.54Yes -
C’ GFP library in Starvation Media

mitochondria278.741.25No -
C’ GFP library on the background of Pup2-DaMP

mitochondria -
C’ GFP library on the background of CCT mutant

mitochondria188.9580.847711No
